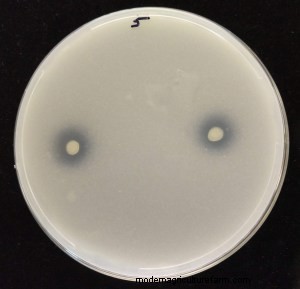

Phosphorus is a critical plant nutrient. It stimulates root growth, is part of photosynthesis and transferring nutrients through the plant, and without, maturity is delayed and fruits and seeds are few and poorly formed. The good news is that there is lots of phosphorous in the soil, with concentrations ranging from 200 to 6,000 pounds per acre. The bad news is that 80 percent of this phosphorus is immobile and not available for uptake by plants. We’ve managed to overcome this problem by adding nutrients to the soil as manure or chemical fertilizers. But erosion and runoff from fields has led to other problems – like algae growth in lakes and streams.
But, today, there’s some good news in the world of phosphorus. A research team led by the University of Washington and Pacific Northwest National Laboratory has shown that microbes taken from trees growing beside pristine mountain-fed streams in Western Washington could make phosphorus trapped in soils more accessible to agricultural crops. The findings were published in October in the journal Frontiers in Plant Science.
 These bacteria are “endophytes,” micro-organisms living within the tissue of a plant as endosymbionts. Sharon Doty, a professor in the UW School of Environmental and Forest Sciences thinks of them as “probiotics” for plants. Doty’s lab has shown in previous studies that microbes can help plants survive and even thrive in nutrient-poor environments — and help clean up pollutants.
These bacteria are “endophytes,” micro-organisms living within the tissue of a plant as endosymbionts. Sharon Doty, a professor in the UW School of Environmental and Forest Sciences thinks of them as “probiotics” for plants. Doty’s lab has shown in previous studies that microbes can help plants survive and even thrive in nutrient-poor environments — and help clean up pollutants.
In this new study, Doty and collaborators found that endophytic microbes isolated from wild-growing poplars helped unlock valuable phosphorus from the environment, breaking apart the chemical complexes that had rendered the phosphorus unavailable to plants.

“We’re harnessing a natural plant-microbe partnership,” Doty said. “This can be a tool to advance agriculture because it’s providing this essential nutrient without damaging the environment.”
Doty’s research scientist, Andrew Sher, and UW undergraduate researcher Jackson Hall demonstrated in lab experiments that the microbes could dissolve the phosphate complexes. Poplar plants inoculated with the bacteria in Doty’s lab were sent to collaborator Tamas Varga, a materials scientist at the Environmental Molecular Sciences Laboratory at Pacific Northwest National Laboratory in Richland, Washington. There researchers used advanced imaging technologies at their lab and at other U.S. Department of Energy national laboratories to provide clear evidence that the phosphorus made available by the microbes did make it up into the plant’s roots.
The imaging also revealed that the phosphorus gets bound up in mineral complexes within the plant. Endophytes, living inside plants, are uniquely positioned to re-dissolve those complexes, potentially maintaining the supply of this essential nutrient.
While previous work in Doty’s lab demonstrated that endophytes can supply nitrogen, obtained from the air, to plants, such direct evidence of plants using phosphorus dissolved by endophytes was previously unavailable.
The bacteria used in these experiments came from wild poplar trees growing along the Snoqualmie River in Western Washington. In this natural environment, poplars are able to thrive on rocky riverbanks, despite low availability of nutrients like phosphorus in their natural habitat. Microbes help these trees capture and use the nutrients they need for growth.
These findings can be applied to agriculture crops, which often sit on an unused abundance of “legacy” phosphorus that has accumulated in the soil from years of fertilizer applications. Microbes could be applied in the soil among young crop plants, or as a coating on seeds, helping to unlock phosphorus held captive and making it available for use by plants to grow. Reducing the use of fertilizers and employing endophytes — such as those studied by Doty and Varga — opens the door for more sustainable food production.
 “This is something that can easily be scaled up and used in agriculture,” Doty said.
“This is something that can easily be scaled up and used in agriculture,” Doty said.
UW has already licensed the endophyte strains used in this study to Intrinsyx Bio, a California-based company working to commercialize a collection of endophyte microbes. The direct evidence provided by Doty and Varga’s research of endophyte-promoted phosphorus uptake is “game-changing for our research on crops,” said John Freeman, chief science officer of Intrinsyx Bio.
This research was funded by the Byron and Alice Lockwood Foundation and the U.S. Department of Energy Office of Science.
Materials from University of Washington press release with edits and additions by Kathy Voth.